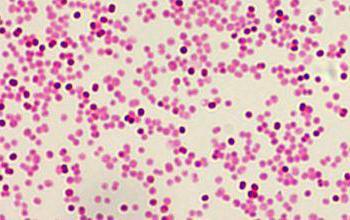
image

Моракселла катаралис несколько десятилетий назад считалась гепатогенной бактерией. А в настоящее время относится к одному из наиболее распространённых возбудителей воспалительных процессов в организме человека. Данный вид микроорганизмов вызывает отиты и синуситы у детей. Также вызывает обострение бронхита у людей во взрослом возрасте.
Следует знать, что Моракселла катаралис является микроорганизмом, чьё нахождение в микрофлоре верхних дыхательных путей человека является естественным. В процентном соотношении у детей, которые болеют отитом, Moraxella catarrhalis присутствуют в большем количестве, чем у тех, кто не подвержен данному заболеванию. Возбудители могут передаваться воздушно-капельным путём или через непосредственный контакт с больным.
Факторы, способствующиеё развитию заболеваний
Из ротовой полости Моракселла катаралис может опуститься ниже в лёгкие и бронхи. При опущении данных микроорганизмов в органы дыхания развиваются такие заболевания, как пневмония и бронхит. Если речь идёт о взрослом человеке, то существуют факторы, которые способствуют развитию этих заболеваний.
- Курение.
- Различные инфекции и вирусы, которыми заражён организм взрослого человека.
- Приём определённых медицинских препаратов. Например, глюкокортикоиды и иммунодепрессанты.
Инфекции
В детском возрасте распространению Моракселла катаралис способствует бронхиальная астма. Малыши более подвержены распространению данного вида микроорганизмов. Ээто связано с тем, что их иммунная система находится на стадии становления. Особенностью данного заболевания является то, что убрать его из организма полностью практически невозможно. У детей Моракселла катаралис в носу может развиться из-за вирусных инфекций, недоношенности.
Moraxella catarrhalis — это аэробный диплококк. Данный микроорганизм является одной из распространённых причин появления отита в детском организме. Также Моракселла катаралис способствует возникновению хронических синуситов.
Бактерия является возбудителем пневмонии. Данная пневмония считается пневмококковой. Около 50% больных имеют летальный исход от других сопутствующих заболеваний.
Носители
Носителями Моракселла катаралис могут быть как дети, так и взрослые. Люди старше восемнадцати подвергаются данным микроорганизмам в небольшом количестве. Примерно 5% населения содержат данные бактерии в своём организме. Существуют регионы большего скопления заражённых. В зимние месяцы число болеющих людей, как правило, выше. В зоне риска находятся дети младенческого возраста. На показатели носительства Моракселла катаралис влияют нижеперечисленные факторы:
- Условия жизни людей.
- Соблюдаемая гигиена.
- Влияние окружающей среды. А именно плохая экологическая обстановка.
- Наследственность, склонность к тем или иным заболеваниям.
- Домашний быт: чистота, опрятность и прочее.
Попадая в дыхательные пути человека, Моракселла катаралис начинает колонизировать. Симптомы попадания данных бактерий и возникновения отита имеют общий характер. А именно кашель с мокротой, в которой присутствует гной и отдышка.
Симптомы прогрессирования заболеваний, вызванных Moraxella catarrhalis
В зависимости от того, какой орган поражён данными бактериями, так и будет проходить данное заболевание.
- В случае когда моракселла попадает в среднее ухо или синус черепа, у ребёнка возникает отит или синусит средней степени тяжести. Данное заболевание сопровождается болевыми ощущениями в ухе. Также появляется высокая температура тела, возможны гнойные выделения. Если находится Моракселла катаралис в носу у ребенка, то наступает заложенность и интоксикация.
- При поражении данными бактериями нижних дыхательных путей, возникают такие заболевания, как бронхит и пневмония. Бактерии Moraxella catarrhalis присутствуют в мокроте пациента. А вот выявить их наличие в крови человека практически невозможно.
Диагностика заболевания
Присутствие данных бактерий в качестве возбудителя в организме определяется путём взятия мокроты или слизистой больного. Далее в лаборатории делается специальный анализ на выявление бактерии в организме человека.
Моракселла катаралис у детей и взрослых. Лечение заболеваний, вызываемых данными бактериями
Существует мнение, что специально избавляться от Moraxella catarrhalis не нужно. И данные бактерии перестанут колонизироваться самостоятельно без назначения лекарств.
Если у пациента присутствует хронический отит или синусит, тогда прописывают препараты с содержанием антибиотиков.
Данная бактерия может бороться с пенициллиновым кольцом первого ряда антибиотиков. Поэтому для лечения заболеваний с возбудителем Moraxella catarrhalis назначают нижеперечисленные препараты:
- «Аугментин» и «Амоксиклав».
- «Зиннат» и «Цефуроксим».
- «Цефтриакон» и «Цефотаксим».
- «Меропинем», «Азитромицин», «Рокситромицин».
Данные препараты подходят для детей. Помимо антибиотиков, для облегчения общего состояния больного врач назначает жаропонижающие средства, противовоспалительные медикаменты, отхаркивающие лекарства. Также назначается инфузионная терапия, если интоксикация организма имеет высокий уровень.
Следует знать, что при появлении симптомов отита, вызванного Moraxella catarrhalis, либо других заболеваний следует как можно быстрее обратиться к врачу. Чтобы он смог провести полное обследование и назначить необходимые препараты, процедуры. Самостоятельное лечение не приветствуется. Так как может быть нанесён вред организму. Особенно осторожными следует быть в отношении с маленькими детками, так как их иммунная система ещё не крепкая.
Небольшое заключение
Теперь вам известно что такое Моракселла катаралис. Лечение недугов, вызываемых этим микроорганизмом, мы также кратко описали. Как и рассказали, какие болезни бактерия может вызывать. Тема диагностики была также рассмотрена в статье. Надеемся, что данная информация была вам полезна.
Моракселла представляет собой бактерию, способную вызывать у детей развитие самых распространенных патологий ЛОР-органов — воспаления среднего уха и околоносовых пазух, а у взрослых – обструктивного бронхита. Это условно-патогенный микроорганизм, обитающий на коже, конъюнктиве глаз, слизистой носа и мочевыводящих путей здоровых людей. Под воздействием негативных эндогенных или экзогенных факторов ослабляется иммунная защита, моракселла приобретает патогенные свойства, что приводит к появлению проблем со здоровьем. Патогенными для человека являются штаммы, вызывающие заболевания у животных — коров и овец.
Моракселла относится к классу неферментирующих грамотрицательных бактерий и обладает соответствующими морфологическими, тинкториальными, биохимическими, физиологическими и культуральными свойствами.
Моракселла вызывает различные патологические процессы преимущественно у детей – синуситы, отиты, кератоконъюнктивиты, менингит, острую респираторную инфекцию. Опасна бактерия тем, что с большим трудом поддается диагностике, а из-за этого лечится долго и безрезультативно. Она устойчива к большинству антибиотиком, которые чаще всего назначают при заболеваниях ЛОР-органов. Эта устойчивость обусловлена способностью продуцировать фермент β-лактамазу.
Moraxella spp являются стабильными индикаторными микробами, характеризующими антропогенное загрязнение водоемов, воздуха и почвы. Загрязнение объектов окружающей среды влечет за собой развитие нагноительных процессов на коже и массовых инфекционных заболеваний, что очень важно в санитарно-эпидемиологическом отношении.
Этиология
Моракселлы – хемоорганотрофы и облигатные аэробы. Они очень прихотливы к условиям роста. В качестве источника энергии используют кислоты и стерины. Для выращивания бактерий в лабораторных условиях используют среды, в которых содержатся различные стимуляторы — кровь, минеральные вещества, витамины или лактат. Моракселлы продуцируют ферменты оксидазу и каталазу, не образуют индол, пигмент, мочевину и сероводород, не расщепляет углеводы и не восстанавливает нитраты. Благоприятный температурный режим для роста и развития бактерий – 35-37 °С.
Moraxella catarrhalis хорошо растет на средах, содержащих кровь или ее компоненты, образуя мелкие гладкие или шероховатые колонии серого цвета с гемолизом или без него. Для выделения чистой культуры используют среды с антибиотиком, подавляющие рост сопутствующей микрофлоры, например, Мюллера—Хинтона.
Факторы патогенности: эндотоксин — липополисахарид клеточной стенки, непосредственно вызывающий заболевание; бахрома, обеспечивающая фиксацию микробов на реснитчатом эпителии.
Эпидемиология
Moraxella catarrhalis — нормальный обитатель организма человека, заселяющий слизистую оболочку респираторного тракта. Микроб обнаруживают в носоглотке здоровых людей. Его количество заметно возрастает в зимнее и осеннее время года. Бактерии встречаются в незначительном количестве на слизистой оболочке шейки матки и уретры у женщин.
Инфекция обычно распространяется аэрозольным или воздушно-капельным путем. В более редких случаях происходит контактное инфицирование. Бактерии выделяются во внешнюю среду вместе с секретом дыхательных путей — мокротой, отделяемым зева, слизью из бронхов. Рото- и носоглотка являются входными воротами инфекции. Возбудитель спускается в трахею и бронхи, проявляет свои патогенные свойства, вызывает местное воспаление, протекающее по типу бронхита или пневмонии.
Факторы, провоцирующие развитие инфекционного процесса:
- Курение,
- Респираторно-синцитиальная и цитомегаловирусная инфекция,
- Легочная дисплазия,
- Дефект межжелудочковой перегородки,
- Лечение глюкокортикостероидами,
- Недоношенность детей,
- Гипогаммаглобулинемия,
- Лейкоз,
- СПИД,
- ХОЗЛ,
- Злокачественные новообразования,
- Интубация трахеи,
- ИВЛ,
- Аспирация содержимого дыхательных путей,
- Хронические заболевания – бронхиальная астма.
Моракселла самостоятельно вызывает развитие патологии или в ассоциации с другими микроорганизмами — стафилококками, стрептококками, гемофилами, энтеробактериями, грибами.
- Менингита,
- Конъюнктивита,
- Септицемии,
- Отита,
- Синусита,
- Бронхита,
- Пневмонии,
- Воспаления мочеиспускательного канала или мочевого пузыря,
- Вентрикулита,
- Перитонита,
- Флегмоны глазницы,
- Эндокардита.
Около 50% больных имеют летальный исход от перечисленных заболеваний. M. catarrchalis является возбудителем госпитальной инфекции.
Носителями Моракселла катаралис является 5% населения. Бактерии содержатся в организме детей и взрослых. Существуют регионы большого скопления зараженных. В зоне риска находятся младенцы.
Факторы, влияющие на показатели носительства Моракселла катаралис:
- Соблюдение личных гигиенических норм,
- Плохая экология,
- Наследственная предрасположенность к определенным заболеваниям,
- Бытовые условия.
Симптоматика
Моракселла попадает в организм человека и начинает колонизировать эпителий верхних дыхательных путей. На эпителиоцитах бактерии активно размножаются и осуществляют свою жизнедеятельность. При снижении местного иммунитета и общей сопротивляемости организма развивается воспаление, которое клинически проявляется соответствующими симптомами.
- При бронхите и пневмонии у больных появляются общие симптомы: лихорадка, озноб, миалгия, артралгия, боль в груди, цефалгия, одышка, разбитость и слабость. К местным признакам воспаления относятся: гиперемия зева, отечность миндалин, боль в горле, увеличение лимфоузлов. Симптомы интоксикации достигают крайней степени выраженности: больных мучает жар и сотрясающий озноб, возникает гипергидроз, головная боль, ломота во всем теле. Кашель является основным симптомом заболевания. Сначала он сухой, мучительный, а затем становится продуктивным с выделением гнойной мокроты.
- При попадании моракселлы в среднее ухо, возникает отит с резкой, стреляющей болью в ухе, нередко иррадиирующуй в зубы, висок, нижнюю челюсть, слизисто-гнойным отделяемым, снижением слуха, общим недомоганием, тошнотой, головокружением, лихорадкой и прочими признаками интоксикации.
- Микробы, проникая в синусы черепа, вызывают синусит. Его симптомами являются: распирающая и давящая боль в области поражения, обильное гнойное отделяемое с прожилками крови, стойкая заложенность носа, кашель с выделением гнойной мокроты в утренние часы, частое чихание, отек кожи над очагомпоражения, отсутствие обоняния, интоксикация.
- Если моракселла катаралис поселяется в носу у ребенка, возникает сухость слизистой, заложенность носа, ринорея, головная боль, ощущение давления в носу, появление гнойных выделений, сухой или влажный кашель, снижение обоняния, заложенность ушей, нарушение сна.
- Данные микроорганизмы способны вызвать воспаление конъюнктивы и роговицы – конъюнктивит, кератит и кератоконъюнктивит. У больных глаза краснеют, склеры инъецируются, появляется слезотечение, светобоязнь и ощущение инородного тела. При несвоевременном оказании медицинской помощи возможна потеря зрения.
- Гематогенным или лимфогенным путем микробы могут проникать в урогенитальный тракт и поражать эпителиоциты с развитием вторичного бактериального уретрита или цистита. Патологический процесс обычно развивается в организме взрослого человека. Больные жалуются на режущие боли во время мочеиспускания, частые позывы, появление гноя или крови в моче, выделения из уретры слизисто-гнойного характера. При осмотре выявляется гиперемия и склеивание губок наружного отверстия уретры.
- В редких случаях моракселлы вызывают эндокардит, менингит, сепсис.
Диагностика
Основными методами диагностики заболеваний, вызванных бактериями из рода Моракселла, являются микробиологический и микроскопический. Бактериологическое исследование клинического материала проводят в несколько этапов: забор материала от больного и доставка его в баклабораторию, изучение готовых препаратов под световым микроскопом, бакпосев на питательные среды с последующей идентификацией микроорганизма до рода и вида.
Из носа и зева больных берут мазок ватным тампоном, который помещают в 2 мл физраствора. Исследование проводят не позднее двух часов от момента взятия материала, поскольку возбудитель неустойчив к факторам внешней среды. Исследуют также кровь и мокроту больных.
Микроскопируют окрашенный по Грамму препарат. В мазке обнаруживают красные кокки, располагающиеся парами или цепочками.
Выбор дополнительных диагностических методик определяется местом локализации патологического процесса. Всем без исключения больным необходимо сдать кровь и мочу на общеклинический анализ. При поражении органов дыхания проводят рентгенологическое или томографическое исследование грудной полости, бронхоскопию, ларингоскопию, риноскопию, изучают функцию внешнего дыхания, измеряют жизненную функцию легких. При синуситах также показан рентген пазух, при отитах — отоскопия, исследование звукопроведения и функционирования звукового анализатора. Лицам с воспалением урогенитального тракта проводят цистоскопию, рентгенографию с контрастным веществом, бакпосев мочи.
Лечение
Моракселла — бактерия. Чтобы от нее избавиться, необходимо пройти курс противомикробной терапии. Без антибиотиков справиться с инфекционным процессом невозможно.
Если в мазке из зева на микрофлору обнаружена моракселла, но при этом отсутствуют типичные жалобы заболевания, лечение не требуется.
Препарат, дозировку и продолжительность приема должен подбирать врач с учетом чувствительности данного микроорганизма, течения и тяжести заболевания, индивидуальных особенностей макроорганизма.
При сильном воспалении и резком ухудшении общего самочувствия больного показано внутривенное введение коллоидных и кристаллоидных растворов, нормализующих водно-электролитный баланс и устраняющих интоксикацию.
После снятия острых признаков воспаления назначают общеукрепляющую терапию, витаминно-минеральные комплексы, иммуномодуляторы, физиотерапевтические процедуры. Эти методы помогают быстрее восстановиться после тяжелого недуга и вернуться к полноценной жизни.
Моракселла — микроорганизм, который не часто встречается в практике клиницистов и редко приводит к тяжелым осложнениям. Несмотря на это, не стоит заниматься самолечением. Только квалифицированный специалист сможет правильно подобрать действенный препарат и вылечить недуг.
Моракселла катаралис ( M. catarrhalis ) представляет собой тип бактерий , который также известен как Neisseria catarrhalis и Branhamella catarrhalis .
Раньше можно считать нормальной часть дыхательной системы человека, но более недавние исследования показывают , что может иногда вызывает инфекцию.
Многие дети младшего возраста имеют M. catarrhalis в их дыхательных путей в течение первых нескольких лет жизни, но это не всегда вызывают инфекции. Когда это происходит, это часто приводит к простому уху или синусита . У детей с ослабленной иммунной системой, это может вызвать более серьезные инфекции, такие как пневмония или бронхит.
Взрослые, с другой стороны, как правило , не имеют M. catarrhalis в их дыхательных путях. Когда они делают, они , как правило , имеют ослабленную иммунную систему из — за основного заболевания, такие как аутоиммунное нарушение , или от лечения , такие как химиотерапия .
Взрослые с условиями легких, в особенности муковисцидоза и хронической обструктивной болезни легких (ХОБЛ) , также более вероятно , разработать M. catarrhalis инфекцию. Это происходит потому , что хронические заболевания легких делают его более трудным для ваших легких , чтобы очистить бактерии.
M. catarrhalis все чаще признаются в качестве общей причины острого среднего отита , также известного как инфекции среднего уха у детей. Многие маленькие дети имеют эти бактерии в их носы, и иногда он может перейти в среднее ухо, вызывая инфекцию.
Пневмония является инфекция в легких, часто вызываемых бактериями. В то время как М. catarrhalis , как правило , не вызывает пневмонию, может у взрослых с ослабленным иммунитетом или хроническими заболеваниями легких. Люди с болезнью легких , которые проводят много времени в больницах имеют самый высокий риск развития пневмонии из — за M. catarrhalis .
Бронхит является воспаление легких , который обычно вызывается вирусом, а не бактерии. Тем не менее, у взрослых с ослабленной иммунной системой или хроническими заболеваниями легких, M. catarrhalis может вызвать бронхит. Как пневмония, бронхит из — за M. catarrhalis является наиболее распространенным у взрослых с заболеваниями легких в больницах.
И пневмония и бронхит производят подобные симптомы, главным из которых является кашель, который производит слизь и часто длится в течение нескольких недель. Однако, симптомы пневмонии, как правило, более серьезны.
M. catarrhalis также может привести к инфекции пазухи у детей, а также взрослых с ослабленной иммунной системой. Симптомы инфекции пазухи похожи на те холода , но , как правило, еще хуже в течение недели , а не лучше. Они могут также вызвать зеленовато-желтые выделения в носу, давление или боль в вашем лице, и лихорадка.
ХОБЛ относится к группе легочных заболеваний , которые ухудшают в течение долгого времени. К ним относятся хронический бронхит , эмфизема легких , и огнеупорной астмы, которая является астма , которая не становится лучше с регулярным лечением.
Основными симптомами ХОБЛ являются кашель, затрудненное дыхание, кашель слизь, стеснение в груди, одышка и затрудненное дыхание.
Хотя ХОБЛ медленно ухудшается с течением времени, инфекции могут ускорить этот процесс и привести к серьезным осложнениям, включая смерть.
М. catarrhalis является второй наиболее распространенной бактериальной причиной ухудшения ХОБЛ. Это может увеличить производство слизи, делают слизь толще, и сделать его еще труднее дышать.
Конъюнктивит , широко известный как розовый глаз, является инфекция наружного слоя глаза. M. catarrhalis может вызвать розовый глаз у детей и новорожденных.
В очень редких случаях, M. catarrhalis может вызвать менингит , особенно у новорожденных. Менингит относится к воспалению мозговых оболочек, которые являются слоями ткани , которые окружают мозг. В то время как в большинстве случаев менингита могут быть предотвращены с вакциной, там нет вакцины для M. catarrhalis не пока.